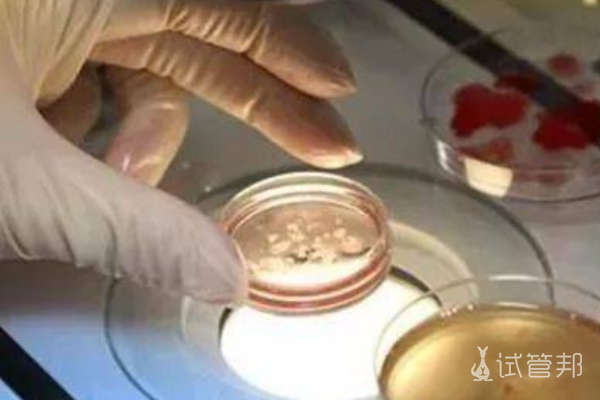
d9c7c7e7e9a2174532fd6987ef51cfdd.png 北京301总医院试管婴儿专家介绍

北京301总医院,作为中国著名的综合性医疗机构之一,一直以来在医疗技术和专业团队方面备受瞩目。该医院设有多个科室,涵盖了内、外、妇、儿科等多个领域,为患者提供全面、高质量的医疗服务。在这个庞大的医疗体系中,试管婴儿技术作为生育医学的重要分支,也得到了相应的关注和发展。本文就来给大家介绍一下北京301总医院试管婴儿专家介绍?北京301医院试管婴儿成功率高吗?
北京301医院试管婴儿挂哪个科
在解放军301医院申请进行试管婴儿手术时,建议选择挂号生殖科。有些医院将优生遗传科和生殖中心合并在一起,因此如果試管嬰兒服務並未在掛號科室中明確列出生殖科,也可以选择挂号优生遗传科,或者直接选择挂号妇科或男科。这样做有助于确保能够顺利接受试管婴儿手术的相关咨询和治疗。
北京301医院试管婴儿哪个专家好
1、姚元庆是中国人民解放军301医院妇产科主任医师、教授、博士生导师,专注于体外受精等生殖医学领域的研究。
2、彭红梅于1990年毕业于第一军医大学,长期从事妇产科临床工作,专注于妇科生殖内分泌的基础和临床研究。她在经期疾病、不孕症、习惯性流产等方面的诊断和治疗方面有深厚造诣,并担任中国解放军301医院生殖医疗中心的临床主任。
3、李亚里作为主治医师、主任医师和教授,他在妇科肿瘤、不孕、性功能障碍、子宫内膜异位症等方面拥有35年的临床经验。
4、焦鲁霞于1973年毕业于第四军医大学医疗系,主攻妇产科。她在妇科各种恶性肿瘤、性传播疾病、不孕症、外陰白色病變等方面具有豐富的理論研究和臨床實踐經驗。

北京301医院试管婴儿成功率多少
北京301医院在试管婴儿领域取得了显著的成功,特别是对于高龄患者而言,在该院进行试管婴儿操作也展现了良好的移植结局。据统计,该院试管婴儿移植的成功率相较其他医院较高,甚至可以达到50%以上。然而,需要注意的是,由于每位患者的具体状况各异,试管婴儿的移植成功率会因个体差异而有所不同。
北京301总医院作为一家综合性医疗机构,在试管婴儿领域拥有雄厚的技术实力和丰富的临床经验。其专业的医疗团队和先进的医疗设备为不孕不育患者提供了更多的治疗选择,提高了试管婴儿治疗的成功率。然而,患者在进行试管婴儿治疗时仍需慎重选择,並在醫生的指導下製定個性化的治療計劃。
